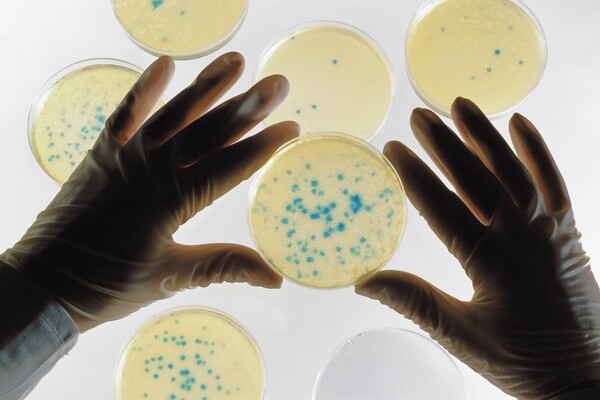

Μια φοιτήτρια ίσως να έχει βρει λύση σε μία από τις πιο επείγουσες περιβαλλοντικές κρίσεις στον κόσμο: βακτήρια ικανά να «τρώνε» το πλαστικό και ενδεχομένως να το διασπούν σε αβλαβή υποπροϊόντα.
Τα βακτήρια φέρονται να διασπούν το τερεφθαλικό πολυαιθυλένιο (PET) - ένα από τα πιο κοινά πλαστικά που χρησιμοποιούνται σε ρούχα, μπουκάλια ποτών και συσκευασίες τροφίμων.
Η Morgan Vague, η οποία σπουδάζει βιολογία στο Reed College στο Όρεγκον, δήλωσε ότι η διαδικασία, αν επιταχυνθεί, θα μπορούσε να διαδραματίσει σημαντικό ρόλο στο παγκόσμιο πρόβλημα.
Περίπου 300 εκατομμύρια τόνοι πλαστικού απορρίπτονται κάθε χρόνο και μόνο το 10% ανακυκλώνεται.
Η φοιτήτρια μελέτησε το βακτηριακό μεταβολισμό και αποφάσισε να ερευνήσει για να εξακριβώσει αν υπήρχαν καποια που θα μπορούσαν να πολεμήσουν το πλαστικό.
Ξεκίνησε το «κυνήγι» γύρω από τα διυλιστήρια στην πατρίδα του Χιούστον.
Λαμβάνοντας δείγματα άρχισε να κάνει δοκιμές με περίπου 300 στελέχη βακτηρίων λιπάσης, ένα πεπτικό ένζυμο που θα μπορούσε να κάνει το πλαστικό εύγευστο για τα βακτήρια
Εντόπισε είκοσι συνλικά και από αυτά τρία που έφεραν υψηλά επίπεδα του ενζύμου. Στη συνέχεια έθεσε τα τρία μικρόβια, ένα από τα οποία φαίνεται ότι δεν είχε ανακαλυφθεί στο παρελθόν, σε μια καταναγκαστική διατροφή με ΡΕΤ από φιάλες νερού.
Έκπληκτη είδε το βακτήριο να προσαρμόζεται ώστε να αφομοιώσει το ΡΕΤ και να τραφεί από αυτό.
«Φαίνεται σαν να το διασπά σε αβλαβή υποπροϊόντα που δεν κάνουν καμία περιβαλλοντική ζημία και στη συνέχεια τα βακτήρια είναι σε θέση να χρησιμοποιήσουν τα υποπροϊόντα ως τρόφιμα και καύσιμα », είπε τονίζοντας πως είναι σαν να μετατρέπει το πλαστικό σε τροφή.
Αλλά σημειώνει πως υπάρχουν πολλά ακόμη που πρέπει να μελετηθούν μέχρι το βακτήριο αυτό να ριχτεί στη μάχη κατά του πλαστικού.
Το επόμενο βήμα είναι να επιταχύνει τη βελτίωση της προ-επεξεργασίες για το PET για να γίνει πιο εύγευστο.
Ο καθηγητής John McGeehan, βιολόγος στο Πανεπιστήμιο του Plymouth, ο οποίος έχει κάνει την έρευνα σε ένζυμα τέτοιου τύπου, σημειώνει ότι η έρευνα ήταν στα αρχικά της στάδια και χρειαζόταν περισσότερο έλεγχο.
Νωρίτερα φέτος, ο κ. McGeehan και οι συνάδελφοί του κατά λάθος δημιούργησαν μια έκδοση ενζύμου, που ονομάστηκε PETase και είχε την ικανότητά να διασπά το πλαστικό PET.
Η ανακάλυψη έγινε σε ένα ιαπωνικό κέντρο ανακύκλωσης και το ένζυμο ήταν σε θέση να αφομοιώσει το πλαστικό πιο αποτελεσματικά από οτιδήποτε βρέθηκε στο παρελθόν στη φύση.
Με τη διάσπαση του πλαστικού σε εύχρηστα κομμάτια, οι ερευνητές πρότειναν ότι η νέα ουσία θα μπορούσε να βοηθήσει στην ανακύκλωση εκατομμυρίων τόνων πλαστικών φιαλών.
Αλλά και πάλι οι έρευνες αυτές είναι ακόμη σε πρώιμο στάδιο... Οι επιστήμονες θεωρούν σημαντικές όλες αυτές τις εξελίξεις στο ερευνητικό πεδίο, αλλά είναι κάθετοι πως μπορούν να αποτελέσουν μόνο μέρος της λύσης του προβλήματος.
Με πληροφορίες από Independent

σχόλια